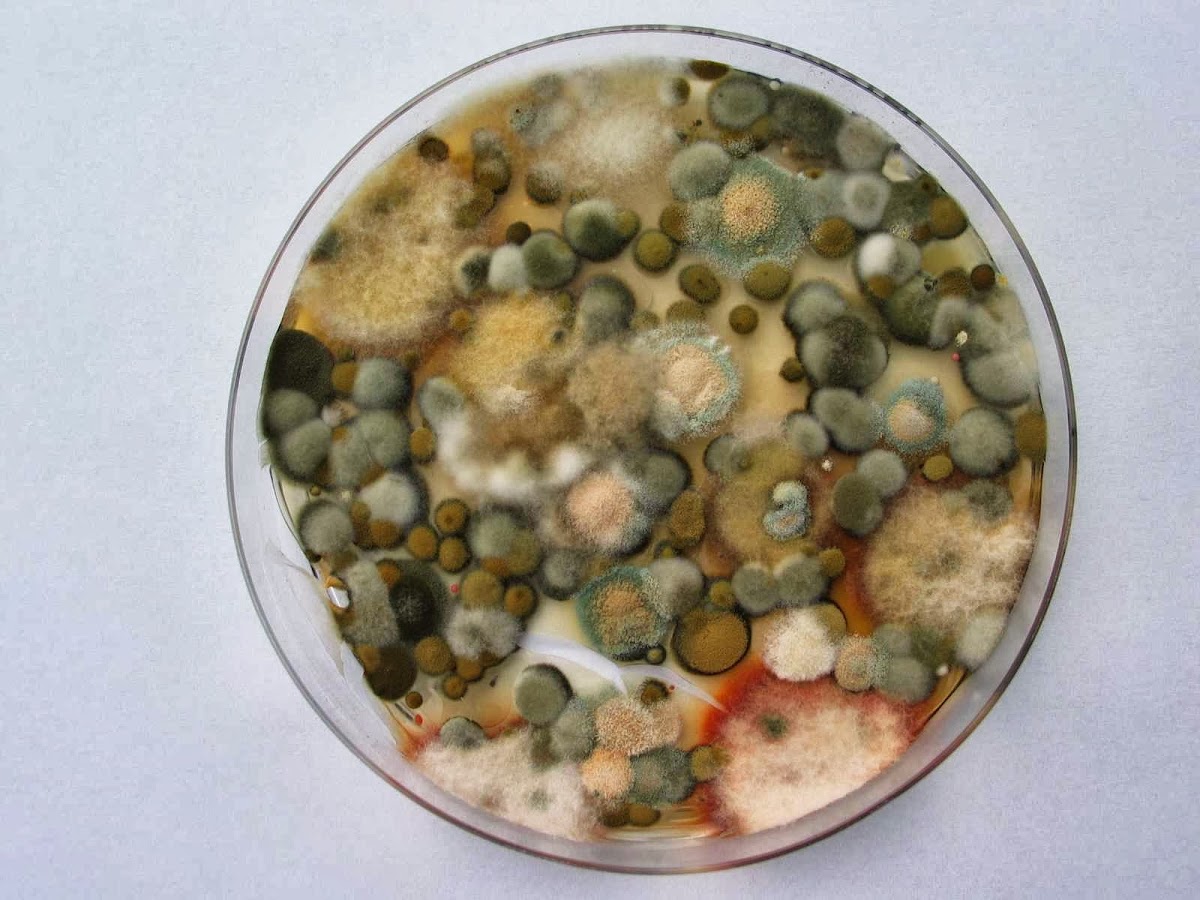
683290049566c

Axel Schäffer
30. March 2026
Herr Sailer hat mich in einer Angelegenheit eines Wassereinbruchs in meiner Eigentumswohnung in München beraten. Er hat ein professionelles Gutachten erstellt, dass den Schaden und die Ursache beleuchtete. Darauf hin konnten Sanierungsmaßnahmen eingeleitet werden. Top Empfehlung.